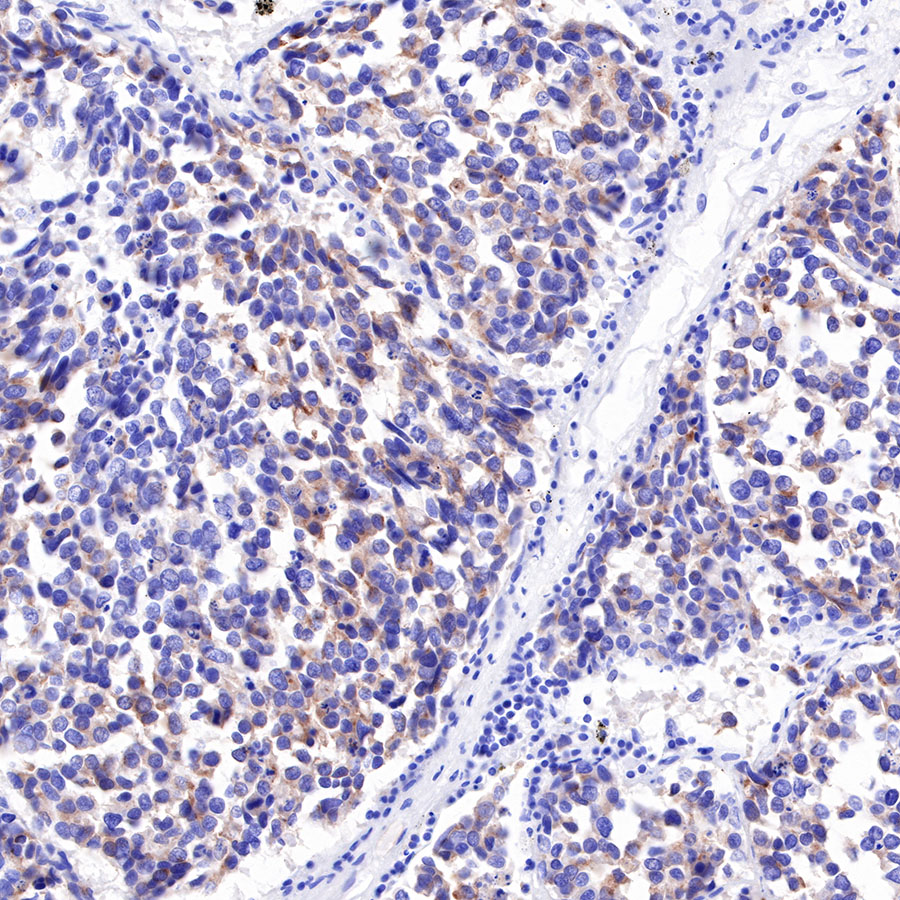

Product Specification
| Host |
Rabbit |
| Antigen |
DLL3 |
| Synonyms |
Delta-like protein 3, Delta3 |
| Immunogen |
Synthetic Peptide |
| Location |
Membrane |
| Accession |
Q9NYJ7 |
| Clone Number |
SDT-207-59 |
| Antibody Type |
Rabbit mAb |
| Application |
WB, IHC-P, ICC, ICFCM |
| Reactivity |
Hu |
| Purification |
Protein A |
| Concentration |
0.5 mg/ml |
| Physical Appearance |
Liquid |
| Storage Buffer |
PBS, 40% Glycerol, 0.05%BSA, 0.03% Proclin 300 |
| Stability & Storage |
12 months from date of receipt / reconstitution, -20 °C as supplied |
Dilution
| application |
dilution |
species |
| ICC |
1:1000 |
|
| IHC-P |
1:1000 |
|
| WB |
1:1000 |
|
| ICFCM |
1:500 |
|
Background
Small cell lung cancer (SCLC) accounts for approximately 15% of all lung cancers. elta-like ligand 3 (DLL3) is an inhibitory Notch ligand that is highly expressed in SCLC and other neuroendocrine tumors but minimally expressed in normal tissues. It is therefore being explored as a potential therapeutic target in SCLC.